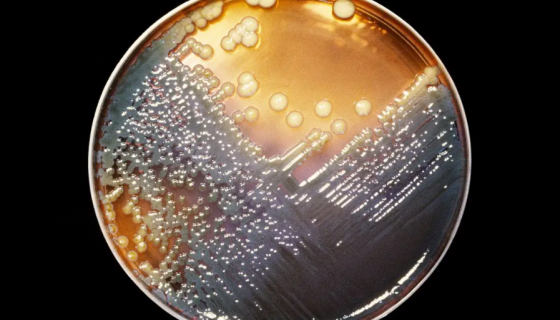
产气肠杆菌的分离和鉴定及用途和检测！
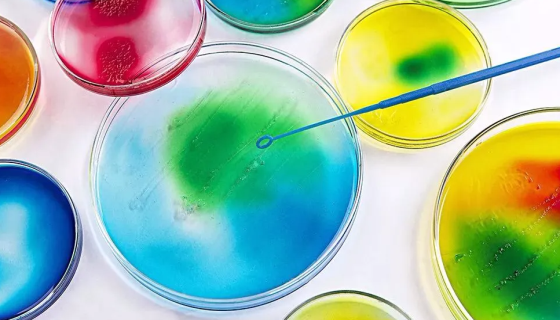
几种常用的微生物染色方法及操作步骤！
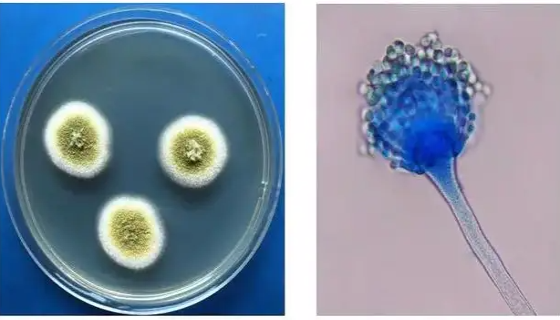
黄色篮状菌的形态特征及培养与保藏方法！

火针层孔菌的培养条件与使用范围及保藏方法!
火针层孔菌是Phellinus属的微生物,原产地为中国。担子...

水生黄杆菌的形态特征与培养方法及打管说明!
水生黄杆菌是Flavobacterium属的微生物,原产地为...

ATCC 55195 惰性乳杆菌 百欧博伟生物
惰性乳酸杆菌是一种常见的细菌,如果患者感染了惰性乳酸杆菌,很...
产气肠杆菌的分离和鉴定及用途和检测!
产气肠杆菌 (Enterobacter aerogenes)...
几种常用的微生物染色方法及操作步骤!
微生物的分类有很多,微生物包括细菌、细胞以及病毒支原体衣原体...

人口腔黏膜癌前病变细胞的培养步骤与操作流程!
人口腔黏膜癌前病变细胞仅用于科研工作,未经许可不得用于其他目...
黄色篮状菌的形态特征及培养与保藏方法!
黄色篮状菌,菌落在CA上25℃培养12天,直径3245mm,...

小鼠角质形成细胞接受后的处理方法与培养步骤!
角质形成细胞是一种不断分化的复层鳞状上皮细胞,其分化的最终阶...

橙黄色黏球菌的储存与培养及冻干管打管说明!
橙黄色粘球菌是Myxococcus属的微生物,原产地为中国。...